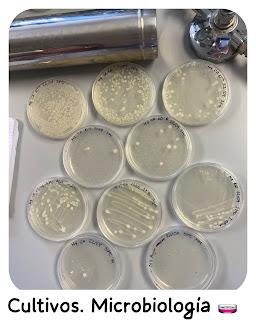
Cultivos MicrobiologĂ­a

đŸ�ą Comiendo en la Uni đŸ�ą

đŸ”Ź Muy buenos dĂas!! đŸ”Ź
¿Qué tal todos? Bien espero!! parece que ya estĂĄ refrescando.., ya era hora!!
Lo mĂĄs destacable esta semana, no por nada especial, sino por novedoso......
Ha sido lo de comer en la Universidad..., y si, como todas las novedades, se pagĂł la novatada..
Por cierto, esta semana le estĂĄn dando mucho al microscopio.. estĂĄn analizando agua de mar (el lunes aprendieron a hacer cultivos que tendrĂan para el martes analizar y diferenciar los detritos fecales de humano y animal)
đŸ�ą Comidas que se ha llevado đŸ�ą
 ⬆️ Sin mezclar ⤵️ Fiambrera lista.
⬆️ Sin mezclar ⤵️ Fiambrera lista. .Ensalada o Poke de Garbanzos.. , arriba veis lo que lleva, ahĂ ya estĂĄ sal - pimentado, luego ella echarĂĄ la salsa. (Le gustĂł mucho, pero se dejĂł las aceitunas.... menos mal que solo le puse 5)También lleva Flan de Queso, y unas pasas y nueces.
.Ensalada o Poke de Garbanzos.. , arriba veis lo que lleva, ahĂ ya estĂĄ sal - pimentado, luego ella echarĂĄ la salsa. (Le gustĂł mucho, pero se dejĂł las aceitunas.... menos mal que solo le puse 5)También lleva Flan de Queso, y unas pasas y nueces.
SĂĄndwich VIPS Club, hecho por mĂ, no el del Vips; creo que me pasé con la mantequilla en el pan. aunque no pareciĂł importarla.Y unas uvas.. ese sĂĄndwich llena mucho, asĂ que no me pareciĂł oportuno ponerle nada mĂĄs.Fue un exitazo!!. Hice para casa también .. pero uff, uno entero llena mucho..., estuve pesada toda la tarde... Y es que cuando pedimos nos comemos menos de uno..
 Macarrones con Carne y Kiwi.El frasco que veis al lado es para el aderezo (todavĂa no habĂa comprado los Ăştiles.. que no te das cuenta hasta que te hace falta).
Macarrones con Carne y Kiwi.El frasco que veis al lado es para el aderezo (todavĂa no habĂa comprado los Ăştiles.. que no te das cuenta hasta que te hace falta).đŸ˜ł Después de superada la novatada.. ha decidido que los dĂas que tenga dos horas entre una clase y otra, viene a casa a comer. (yo creo que es un error, pierde una hora.. que podrĂa aprovechar en la Biblioteca.. teniendo en cuenta la falta de tiempo)đŸ”Ľ La bata el lunes vino quemada, pero no mucho.đŸ”Ź Y ya el mismo lunes se notĂł la carga de trabajo..., en principio tenĂa que haber visto el dĂa anterior que prĂĄctica harĂan (ella pensĂł que era una introducciĂłn y no se querĂa ni llevar la bata.. menos mal que la convencĂ).El caso es que como no sabĂa de que iba la prĂĄctica.. como pollo sin cabeza.. y encima.. la pusieron a una pareja.. que no querĂa ponerse..., asĂ que "todo mal". ( el martes mejorĂł la cosa y acabaron de hacer la prĂĄctica las segundas del grupo.. con lo que salieron una hora antes).Ya a la vuelta le tocĂł hacer un informe de lo que habĂan hecho (porque al final de 8 prĂĄcticas les harĂĄn examen.. ), y también se hizo un resumen de la prĂĄctica del dĂa siguiente, para "no ir como pollo sin cabeza", y claro esto lo ha tenido que hacer todos los dĂas.. ademĂĄs de hacer los esquemas de las clases teĂłricas, mĂĄs los esquemas de la prĂĄcticas del resto de las asignaturas (Meca, Bota y Zoo).Excesivo trabajo.. que le ha tocado ponerse al dĂa en el fin de semana.*abajo os pondré el calendario de la semana pasada para que os hagĂĄis una idea de lo que estoy hablando.
 El martes, JuliĂĄn y yo, comimos fuera.. tuvimos que llevar el coche al mecĂĄnico, se esperaba que tardasen un par de horas, asĂ que mientras ellos solucionaban, nosotros comĂamos...
El martes, JuliĂĄn y yo, comimos fuera.. tuvimos que llevar el coche al mecĂĄnico, se esperaba que tardasen un par de horas, asĂ que mientras ellos solucionaban, nosotros comĂamos... Y pedimos ambos uno de los platos nuevos. Tienen 4 platos nuevos, aunque en el Vips Smart solo tenĂan dos de ellos, el de Pollo y el de Ternera, pedimos ambos Pollo, JuliĂĄn hubiera pedido el de SalmĂłn, pero no lo tenĂan.
Y pedimos ambos uno de los platos nuevos. Tienen 4 platos nuevos, aunque en el Vips Smart solo tenĂan dos de ellos, el de Pollo y el de Ternera, pedimos ambos Pollo, JuliĂĄn hubiera pedido el de SalmĂłn, pero no lo tenĂan. El menĂş viene con bebida y postre o café; Yo pedĂ una tortita con caramelo y nata, y JuliĂĄn dos bolas de helado de chocolate.
El menĂş viene con bebida y postre o café; Yo pedĂ una tortita con caramelo y nata, y JuliĂĄn dos bolas de helado de chocolate.Pollo Piri - Piri: Con toque picante đŸŒś️ con pico de gallo y mango, salteado de champiùón đŸ�„đŸŸŤ Portabello y remolacha sobre hummus, zanahoria đŸĽ• asada con queso feta y compota de arĂĄndanos con frutos secos , y ensalada de espinaca y rĂşcula. AcompaĂąado de pan de masa madre.
Nos gustĂł muchĂsimo, repetiremos.
El café nos lo tomamos en el Häagen-Dazs y dimos una vuelta por el Centro Comercial, compré un par de almohadas para la cama en el Corte Inglés.

Y sobre las 17.30 fuimos a por el coche y para casa..Y las novedades a lo largo de la semana:
 ⤴️ Fue el cumple de Mireya (compaĂąera de clase) y la hizo una flor de Hama beads en 3D, muy chula quedĂł.⤵️ Me volvieron a elegir en Influenster para probar este perfume: Good Girl Blush de 30ml.
⤴️ Fue el cumple de Mireya (compaĂąera de clase) y la hizo una flor de Hama beads en 3D, muy chula quedĂł.⤵️ Me volvieron a elegir en Influenster para probar este perfume: Good Girl Blush de 30ml. ⤵️ Me tocĂł una rutina capilar de Valquer... genial para el cabello de Alejandra.
⤵️ Me tocĂł una rutina capilar de Valquer... genial para el cabello de Alejandra. đŸŽ‰ Si mi madre el 5 de Junio, cumpliĂł 86 aĂąos, el pasado 27 de septiembre (justo 10 dĂas después que el mĂo), fue mi tĂa Pita quién los cumplĂa.
đŸŽ‰ Si mi madre el 5 de Junio, cumpliĂł 86 aĂąos, el pasado 27 de septiembre (justo 10 dĂas después que el mĂo), fue mi tĂa Pita quién los cumplĂa. đŸŽ‚ En Octubre se vienen 3 cumpleaĂąos (JuliĂĄn, su hermana Mari, la hija de esta, Paula)..., yo sigo sin celebrar el mĂo...., a ver si ahora que estĂĄ el coche arreglado, podemos ir algĂşn finde a comer a algĂşn sitio...
đŸ“ş Ha empezado la nueva temporada de Caballos Lentos (Slow horses), seguimos viendo la serie de Alien (algunos bichos me dan mucho asco), y ya os hablaré de ella, pero estoy enganchada porque me parto de risa a Ghosts (a la serie americana, no la inglesa), y sĂ, también teneos tenis, esta vez el Atp de Tokio con Alcaraz y el Atp de Pekin, con Davidovich (estamos haciendo la gira asiĂĄtica).
đŸŽŽ Y este fin de semana ha sido "Mig Any" (Medio aĂąo), se vuelven a vestir de Moros y Cristianos, pero en vez de durar las fiestas tanto, solo duran un fin de semana.. (AquĂ estamos en fiestas un dĂa si y otro también). Nueva ediciĂłn del Mig Any, la festividad que marca el ecuador en las fiestas de Moros y Cristianos. El evento, organizado por la FederaciĂłn UniĂłn de Comparsas Ber-Larga, presenta una agenda marcada por la pĂłlvora, la mĂşsica, los desfiles y un ambiente festero inigualable en todo el municipio y en el solar de la Festa, que se transformarĂĄ en una gran zona verde en el futuro.Y este aĂąo con una efeméride todavĂa mĂĄs especial, pues se cumple el 50 aniversario de los Moros y Cristianos. AsĂ, miles de sanvicenteros y sanvicteras volverĂĄn a salir a la calle desde el viernes 26 hasta el domingo 28 de septiembre para disfrutar de las distintas actividades lĂşdicas y, sobre todo, de la gran Entraeta, en la que las veinte comparsas que integran los bandos moro y cristiano desfilarĂĄn con el colorido habitual de sus trajes.** Cortan las calles, cambian el sentido de los autobuses y los horarios ** Y como de costumbre, hay tanto ruido, tanta fiesta, tantos fuegos artificiales... que no podemos oĂrnos en casa...
Como os comentaba arriba, aquĂ tenéis la semana de trabajo de Alejandra.. que acabarĂĄ el miércoles de esta.

22-26 Septiembre.
Arriba en morado pone: Que tienen que entregar el informe de la Salida de Campo de ZoologĂa antes del dĂa 29/09.
Lunes: 11-13 PrĂĄcticas de Microbiologia, 15 -16 h TeorĂa de Micro, 16-17 ZoologĂa, 17-18 ZoologĂa.Martes: 11-14 PrĂĄcticas de Micro; 3 horas teĂłricas de Zoo,QuĂmica y Bota; y 2 horas de prĂĄctica de ZoologĂa. (estrenaron el Kit de DisecciĂłn)Miércoles: Fue el mĂĄs liviano, en cuanto a tiempo, 3 horas, de las cuales la primera fue teorĂa de MecĂĄnica de Fluidos y onda, y dos horas también de FĂsica, pero de prĂĄctica (problemas /taller) con el otro profesor que no se enteran..Jueves Siguen con las prĂĄcticas de MicrobiologĂa 3 horas, retoman a las 15 horas, con 3 clases teĂłricas de QuĂmica, Meca y Zoo.
Lunes: 11-13 PrĂĄcticas de Microbiologia, 15 -16 h TeorĂa de Micro, 16-17 ZoologĂa, 17-18 ZoologĂa.Martes: 11-14 PrĂĄcticas de Micro; 3 horas teĂłricas de Zoo,QuĂmica y Bota; y 2 horas de prĂĄctica de ZoologĂa. (estrenaron el Kit de DisecciĂłn)Miércoles: Fue el mĂĄs liviano, en cuanto a tiempo, 3 horas, de las cuales la primera fue teorĂa de MecĂĄnica de Fluidos y onda, y dos horas también de FĂsica, pero de prĂĄctica (problemas /taller) con el otro profesor que no se enteran..Jueves Siguen con las prĂĄcticas de MicrobiologĂa 3 horas, retoman a las 15 horas, con 3 clases teĂłricas de QuĂmica, Meca y Zoo.
Y terminaron el Viernes con 2 horas de laboratorio de MicrobiologĂa, retomaron. las 15h con 3 horas teĂłricas de Micro, QuĂmica y BotĂĄnica, para seguir hasta las 20.30 con mĂĄs BotĂĄnica.Y esta semana que se inicia tiene 3 dĂas con prĂĄctica maĂąana y tarde, pero el dĂa que se queda a comer allĂ es solo el martes (bocata de lomo con tomate me ha dicho), ya que el lunes y el miércoles tiene entre medias 2 horas, asĂ que sube a casa, come y baja. Y ya el dĂa 6 termina las prĂĄcticas de MicrobiologĂa, y al final les harĂĄ un examen de todas las prĂĄcticas que han tenido.Y si no cambia la cosa el dĂa 7 tendrĂĄn examen de BotĂĄnica (de la teorĂa).Ya las clases serĂĄn por la tarde en distintos horarios (15-21.30), y tendrĂĄn una semana complicada en Noviembre, y otra semana en Diciembre (8-21.30)Y aquĂ os dejo lo que han hecho esta semana en prĂĄcticas... en el instagram de Alejandra ⏬
Ver esta publicaciĂłn en InstagramUna publicaciĂłn compartida de Alejandra Soto Arias (@alejandra.soto06)

